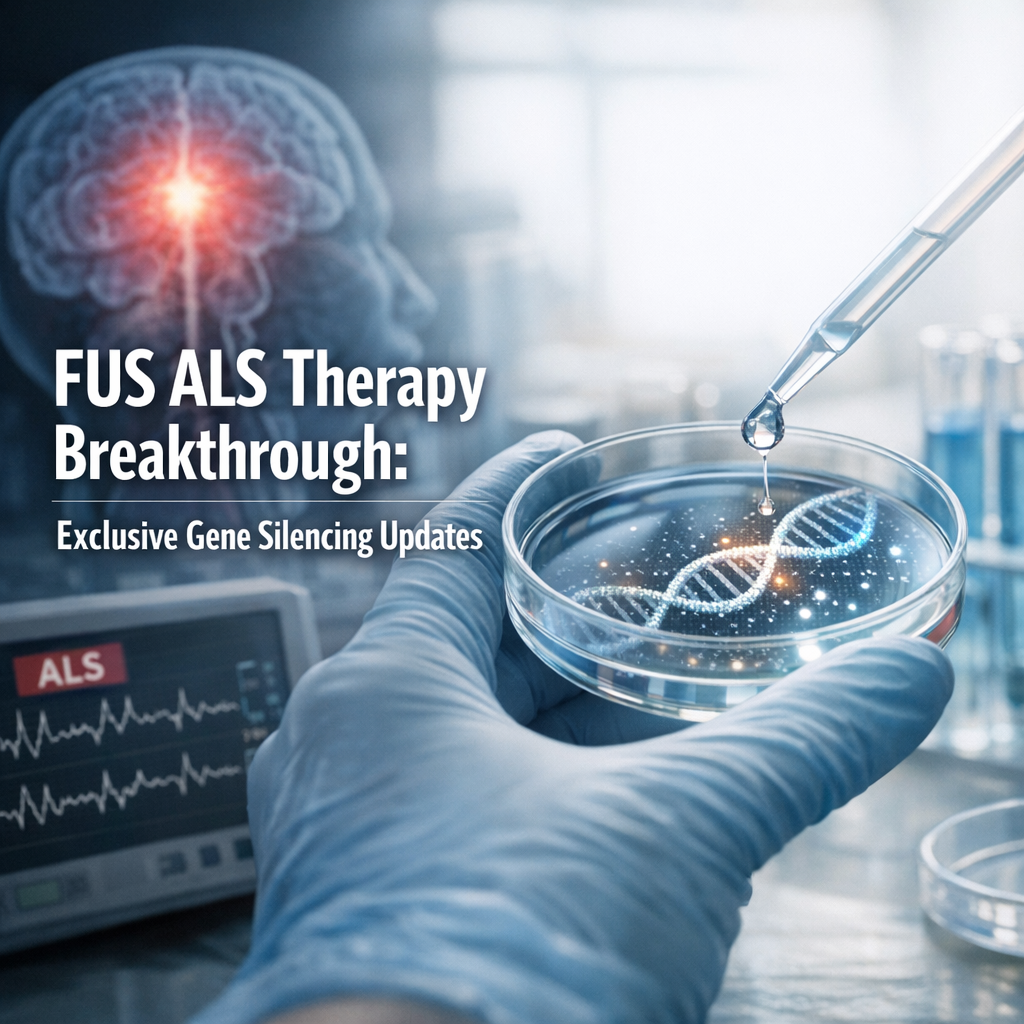
Illustration of FUS ALS Therapy Breakthrough: Exclusive Gene Silencing Updates

ALS Oral Suction & Electric Toothbrush: Best & Effortless Picks
Discover how ALS oral suction and a specialized electric toothbrush can make oral care safer, easier, and more comfortable for those living with ALS—empowering independence while promoting better health every day.